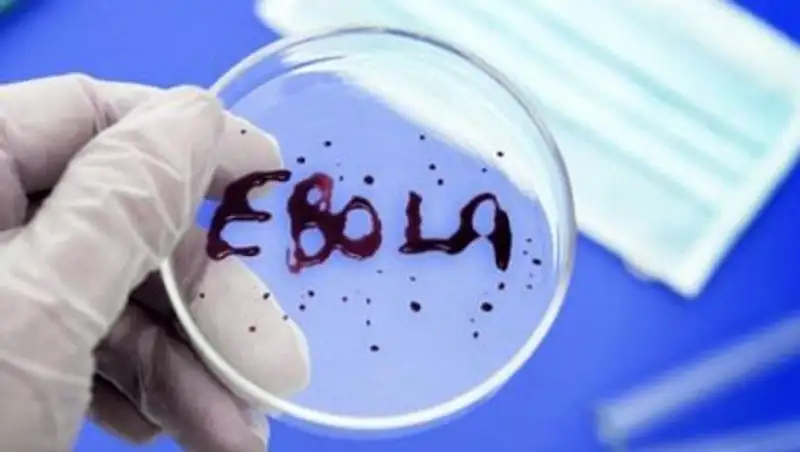
Казахстан через спецфонд ООН оказал помощь странам Африки по борьбе с вирусом Эбола

ВОЗ: распространение вируса Эболы в Западной Африке замедлилось
 Zakon.kz
Zakon.kz
Эффективность борьбы с вирусом будет зависеть от предпринятых мировым сообществом усилий до начала сезона дождей, считают в организации.
Эффективность борьбы с болезнью, вызванной вирусом Эбола (БВВЭ), будет зависеть от предпринятых мировым сообществом усилий до начинающегося в апреле-мае в Западной Африке сезона дождей. Такую точку зрения высказал в Женеве помощник генерального директора Всемирной организации здравоохранения (ВОЗ) Брюс Эйлвард, сообщает ИА ТАСС.
"Если войти с этой болезнью во влажный сезон, то потребуется еще один трудный год или больше (для борьбы с ней)", - отметил он. Эйлвард сообщил, что ВОЗ на данный момент не хватает 260 млн долларов для продолжения борьбы с Эболой. В ближайшие шесть месяцев на эти цели планировалось израсходовать в общей сложности 350 млн долларов.
Эти средства необходимо получить до середины февраля. "К середине февраля у нас закончатся средства - за 4-5 месяцев до того, как этот вирус, по наилучшему из сценариев, мог бы быть остановлен", - сказал помощник генерального директора ВОЗ.
Как считают в Организации, сейчас имеются предпосылки для достижения решающего удара в борьбе с БВВЭ. Ее распространение в Западной Африке замедлилось. За последние три недели в Сьерра-Леоне было зарегистрировано 463 новых случая болезни, в Гвинее - 109, в Либерии - 21. "Это самые низкие показатели за последние три-четыре месяца, - отметил Эйлвард. - Это реальное существенное сокращение".
По данным ВОЗ, с момента начала эпидемии вирусом Эбола в Западной Африке заразились 21797 человек. Из них 8524 - в Либерии, 10,4 тыс. - в Сьерра-Леоне и 2873 - в Гвинее.
Поделитесь новостью
Читайте также
Если вы видите данное сообщение, значит возникли проблемы с работой системы комментариев. Возможно у вас отключен JavaScript